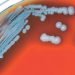
Detectan bacteria mortal en agua y suelo de EU

Tras ser permanente el documento en Tamaulipas, en una semana acudieron más de 600 usuarios a la Oficina Fiscal para solicitarla
MARIO AGUILAR
Gran demanda en el trámite de licencias de manejo es la que se ha generado en Nuevo Laredo tras ser este documento ya permanente en Tamaulipas desde el pasado 20 de julio.
La Oficina Fiscal de Nuevo Laredo a través de su titular Arturo San Miguel Cantú confirma que tramite se ha disparado y todos los días son mas de 180 gentes las que se están atendiendo, incluso ciudadanos con el documento aún vigente, pero que quieren aprovechar el beneficio para ya no pagar cada 2 o 3 años que se tenían que renovar.
San Miguel Cantú, indicó que han tenido una muy buena respuesta por parte de la ciudadanía el trámite y así seguirán atendiendo en base a la capacidad de la oficina fiscal.
“Desde el miércoles 20 de julio el Gobierno del Estado de Tamaulipas a través de la Secretaría de Finanzas, puso a disposición de todos los ciudadanos, la nueva licencia de conducir en esta nueva versión permanente.
Hemos tenido una muy buena respuesta, diariamente estamos atendiendo a mas de 120 personas diarias, se ha incrementado a mas de un 50% el tramite este trámite”, indicó el Jefe de la Oficina Fiscal de Nuevo Laredo, Arturo San Miguel Cantú.
Detalló que de los más de 600 trámites que se han realizado, el 20 por ciento de ellos son ciudadanos que pese a tener su licencia vigente, han buscado aprovechar los descuentos en las nuevas.
Es importante recalcar que la licencia permanente es para chofer, automovilista y motociclista.
Esto quiere decir que se conservan las vigencias de las licencias para aprendiz (menores de 16 y 17 años) y para servicio público.
El costo de la licencia para chofer tiene un costo de 1, 443 pesos y la de automovilistas o motociclista 1, 155 pesos, adultos mayores tienen un descuento del 50%.
Existe el riesgo que el gobierno del estado entrante cancele el decreto que hace a la licencia permanente en Tamaulipas como ocurrió en la Ciudad de México, por ello es importante tramitarla ahora, ya que ese documento aunque se emita un nuevo decreto seguirán teniendo vigencia indefinida.